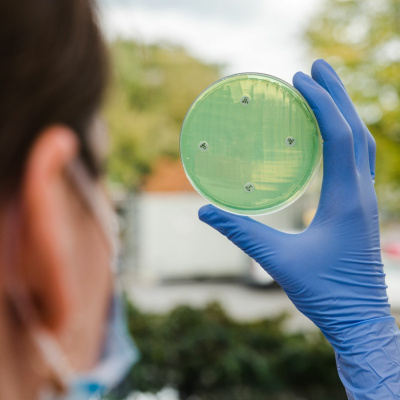
Spør En Forsker

Spør En Forsker
Forskningspodden #32: Hva skal vi gjøre når antibiotika slutter å fungere?
- Autor: Vários
- Narrador: Vários
- Editor: Podcast
- Duración: 0:20:28
- Mas informaciones
Informações:
Sinopsis
I denne episoden av Forskningspodden får du høre hva noen av Norges fremste forskere på antibiotikaresistens gjør for å hindre at vi en dag står uten virksom medisin mot betennelser. Forskningspodden er laget i forskning.no sitt studio av Anne Synnevåg. Hosted on Acast. See acast.com/privacy for more information.